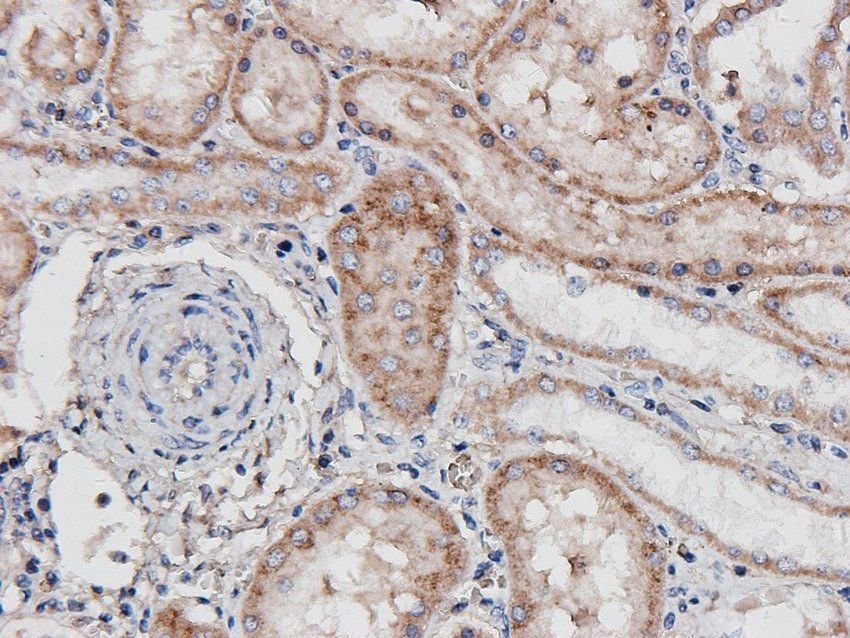
FCRL4 Rabbit Polyclonal Antibody

You have no items in your shopping cart.
All Products
- Featured
 FCRL4 Rabbit Polyclonal Antibody [orb183672]Featured
FCRL4 Rabbit Polyclonal Antibody [orb183672]Featured
IHC-P, WB
Guinea pig, Human, Mouse, Porcine, Rat
Rabbit
Polyclonal
Unconjugated
1 mg, 100 μg - Featured
 CD19 Rabbit Polyclonal Antibody [orb251482]Featured
CD19 Rabbit Polyclonal Antibody [orb251482]Featured
ELISA, ICC, IF, IHC-P
Bovine, Equine, Guinea pig, Human, Mouse, Porcine, Rat
Rabbit
Polyclonal
Unconjugated
100 μg - NRSF REST Protein Rabbit Polyclonal Antibody [orb251478]
ELISA, IHC-P
Human, Mouse, Rat
Rabbit
Polyclonal
Unconjugated
100 μg - Featured
 CXCL14 Rabbit Polyclonal Antibody [orb11354]Featured
CXCL14 Rabbit Polyclonal Antibody [orb11354]Featured
ELISA, IHC-P, WB
Human, Mouse, Rat
Rabbit
Polyclonal
Unconjugated
100 μg - Rabbit IgG (H&L) Antibody Biotin Conjugated [orb347769]
ELISA, IHC, WB
Rabbit
Donkey
Polyclonal
Biotin
2 mg